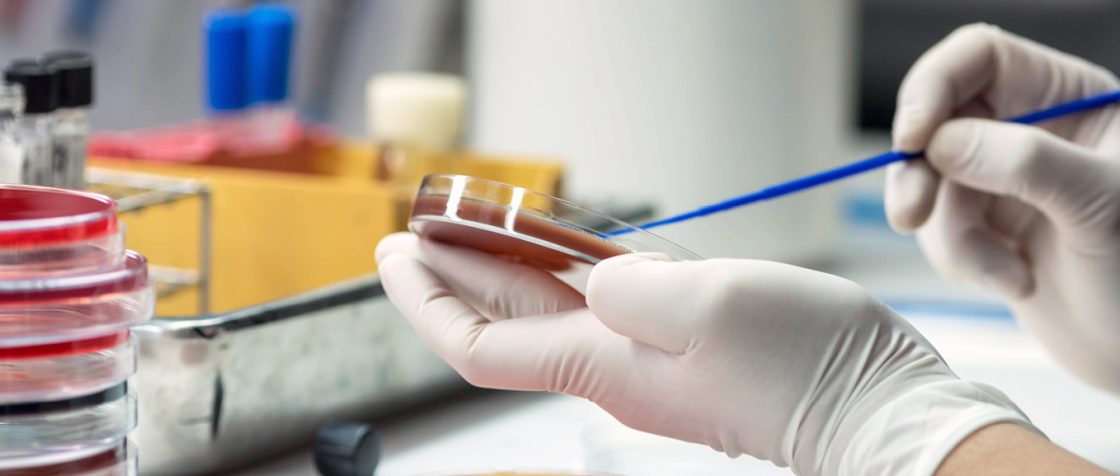

Due: March 9, 2026
The Department of Health and Human Services (HHS) Defense Production Act (DPA) Title III Program is interested in submissions that strengthen the Nation’s security of supply for at least one (1) key starting material (KSM), drug substance, and/or drug product identified within the FDA’s List of Essential Medicines, with a preference for submissions that focus on Anti-Microbials and Large Volume Parenterals.
Responding to this opportunity requires membership in the BioMap Consortium. This Consortium releases numerous solicitations throughout the year, so even if this opportunity may not end up being right for you, we strongly encourage you to join, so you are ready for the next opportunity.
Complete the form below and a program representative will reach out to you shortly to support you through the process.